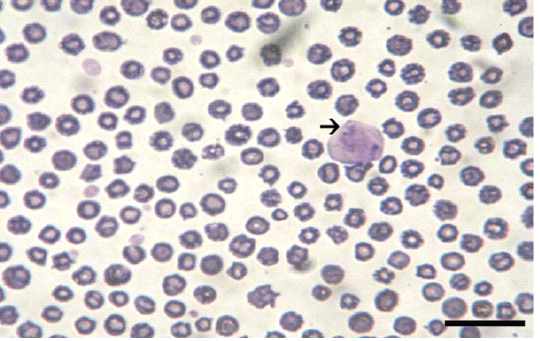

Journal of Animal Health and Production
Research Article
J. Anim. Health Prod. 8(3): 150-157
Figure 1
Blood film showing macro schizont of Theileria annulata (bar=20 µm)
Figure 2
PCR findings of T. annulata infected samples. Ladder of 100 base pair. (2-5) control -ve, (6-10) T. annulata +ve samples of 768 bp.